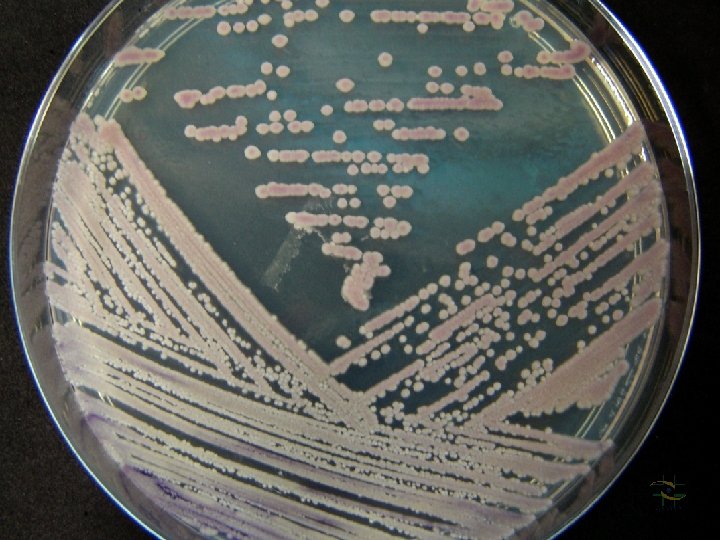
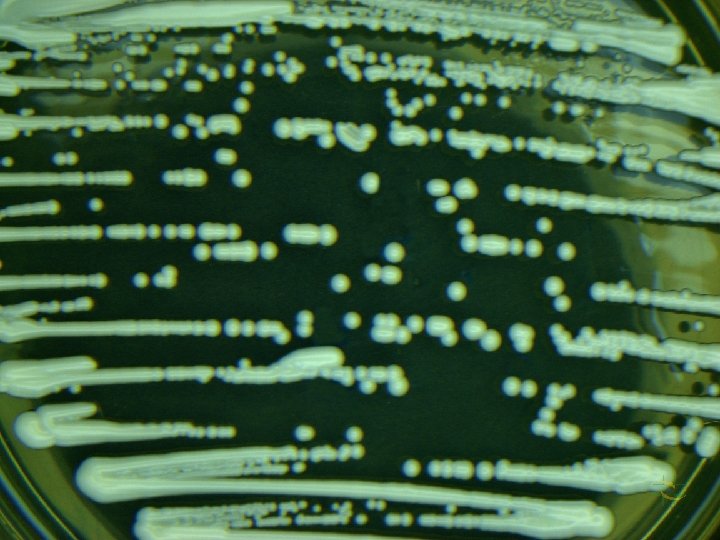
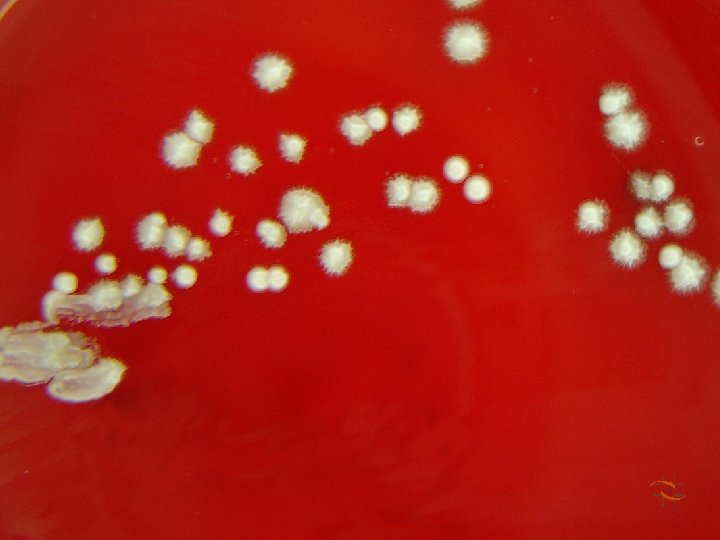
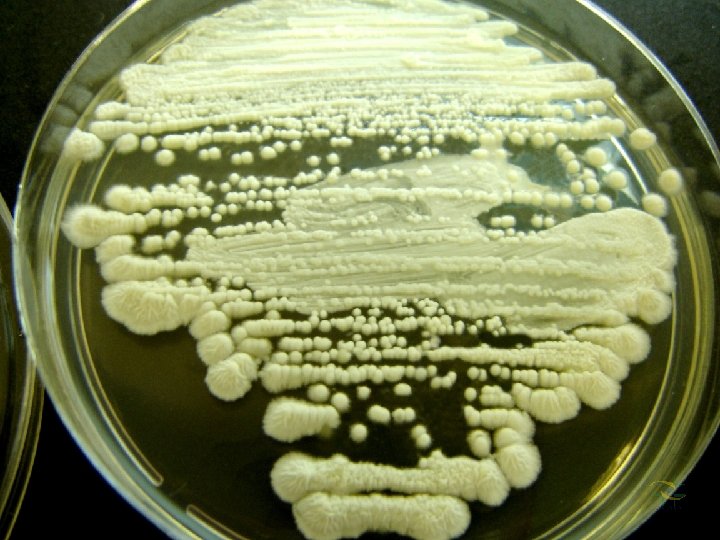

Identificao de Leveduras de Interesse Mdico Gisele Madeira







































- Slides: 39

Identificação de Leveduras de Interesse Médico Gisele Madeira Duboc de Almeida(1), Adriana Motta (1), Maria Walderez Szeszs (2), Sandra Regina Brasil S. Pukinskas (2) 1 Setor de Micologia do Laboratório de Microbiologia do Hospital das Clínicas, Faculdade de Medicina da Universidade de São Paulo 2 Seção de Micologia do Instituto Adolfo Lutz de São Paulo

Testes para identificação Tubo germinativo positivo Tubo germinativo negativo Macromorfologia em meios cromogênicos Candida albicans Candida tropicalis Candida krusei Macromorfologia e micromorfologia das principais espécies Candida albicans Candida krusei Candida glabrata Candida parapsilosis Trichosporon spp Rhodotorula spp micromorfologias Índice

Tubo Germinativo Positivo Candida albicans Teste do Tubo germinativo Formação do tubo diretamente da célula leveduriforme


Tubo Germinativo Negativo outras leveduras Teste do Tubo germinativo CUIDADO: observar a constricção entre a célula mãe (blastoconídio) e o início da formação da pseudohifa.


Candida albicans Macromorfologia em Chromagar Colônias verdes


Candida krusei Macromorfologia em Chromagar Colônia rosa

Candida tropicalis Macromorfologia em Chromagar Colônias azuis


Candida albicans Macromorfologia Ágar Sabouraud: colônias de cor branca a creme, cremosas e lisas. Em ágar sangue, colônias de cor creme, com formação de franjas que lembram “ estrelas”.

Candida krusei Macromorfologia (ágar Sabouraud) Colônias de cor creme, achatadas e com franjas


Candida glabrata Macromorfologia (ágar Sabouraud) Colônias de cor branca a creme, de textura cremosa.


Candida parapsilosis Macromorfologia (ágar Sabouraud) Colônias de cor creme. Podem lembrar “renda”.


Trichosporon spp Macromorfologia (ágar Sabouraud) Colônias de cor creme, podem escurecer com o tempo. Aspecto seco e rugoso

Rhodothorula spp Macromorfologia (ágar Sabouraud) Colônias de cor laranja a vermelha, aspecto cremoso.


Candida albicans Micromorfologia Pseudohifas: abundantes e ramificadas Clamidósporos terminais estruturas arredondadas de parede espessa 2 Blastoconídeos são ovais e formam aglomerados no septo das pseudohifas.


Candida tropicalis Micromorfologia Blastoconídios únicos ou em pequenos grupos ao longo de pseudohifa Pseudohifa abundante, ramificada com verticilos de blastoconídios dispostos em cadeias simples, ramificadas ou irregulares.


Candida parapsilosis Micromorfologia Blastoconídios aparecem de forma única ou em pequenos aglomerados ao longo da pseudohifa. Pseudohifa tem como características marcantes a aparência tortuosa ou curva, largas, denominadas pseudohifas gigantes.


Candida krusei Micromorfologia Blastoconídios são ovais, cilíndricos, dispostos verticiladamente na constrição da pseudohifa. Lembram “palitos de fósforo amontoados”. Pseudohifas Alongadas, delgadas e ramificam lembrando “ galhos de árvores”


Candida glabrata Micromorfologia Blastoconídios são pequenos, ovais ou com gemulação terminal única. Não há formação de pseudohifa.


Rhodotorula spp Micromorfologia Blastoconídios: células redondas ou ovais, com gemulação e raramente apresentam pseudohifa.


Trichosporon spp Micromorfologia Hifa hialina septada verdadeira fragmenta-se em artroconídios ovais ou retangulares. Presença de pseudohifas Presença de blastoconídio único ou de cadeia curta.
